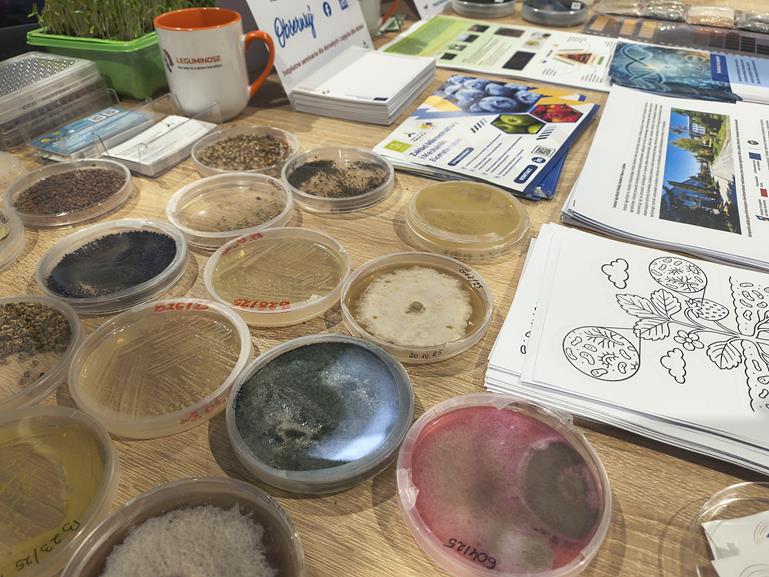

Z przyjemnością informujemy, że w dniach od 7-8 lutego 2026 r. podczas Targów Rolniczych Agro-Park mieliśmy możliwość zaprezentowania naszego projektu pt. „Holobiont roślinny i mikrobiom glebowy szansą dla zrównoważonej produkcji i zdrowia agroekosystemów”, mający na celu zrozumienie i wykorzystanie interakcji gleba–roślina–mikrobiom w kontekście zrównoważonej produkcji rolniczej poprzez badania nad holobiontem roślinnym oraz mikrobiomami glebowymi, a także upowszechnienie wiedzy na temat ich znaczenia dla zdrowia agroekosystemów i społeczeństwa..
Również, w trakcie Targów zaprezentowaliśmy naszą aplikację HoloBIOme w wersji beta, która umożliwia dostęp do wyników analiz mikrobiomów 70 gatunków roślin. Zawiera informacje o bakteriach i grzybach w glebie i roślinach, wspierając zrównoważoną produkcję roślinną i monitorowanie zdrowia agroekosystemów. Aplikacja będzie bezpłatna i będzie regularnie aktualizowana, dostarczając cennych danych rolnikom, badaczom oraz studentom.
Targi Rolnicze Agro-Park w tym roku zostało wyjątkowym miejscem spotkań branżowych liderów, prezentujących najnowsze rozwiązania i innowacyjne techniki rolnictwa.